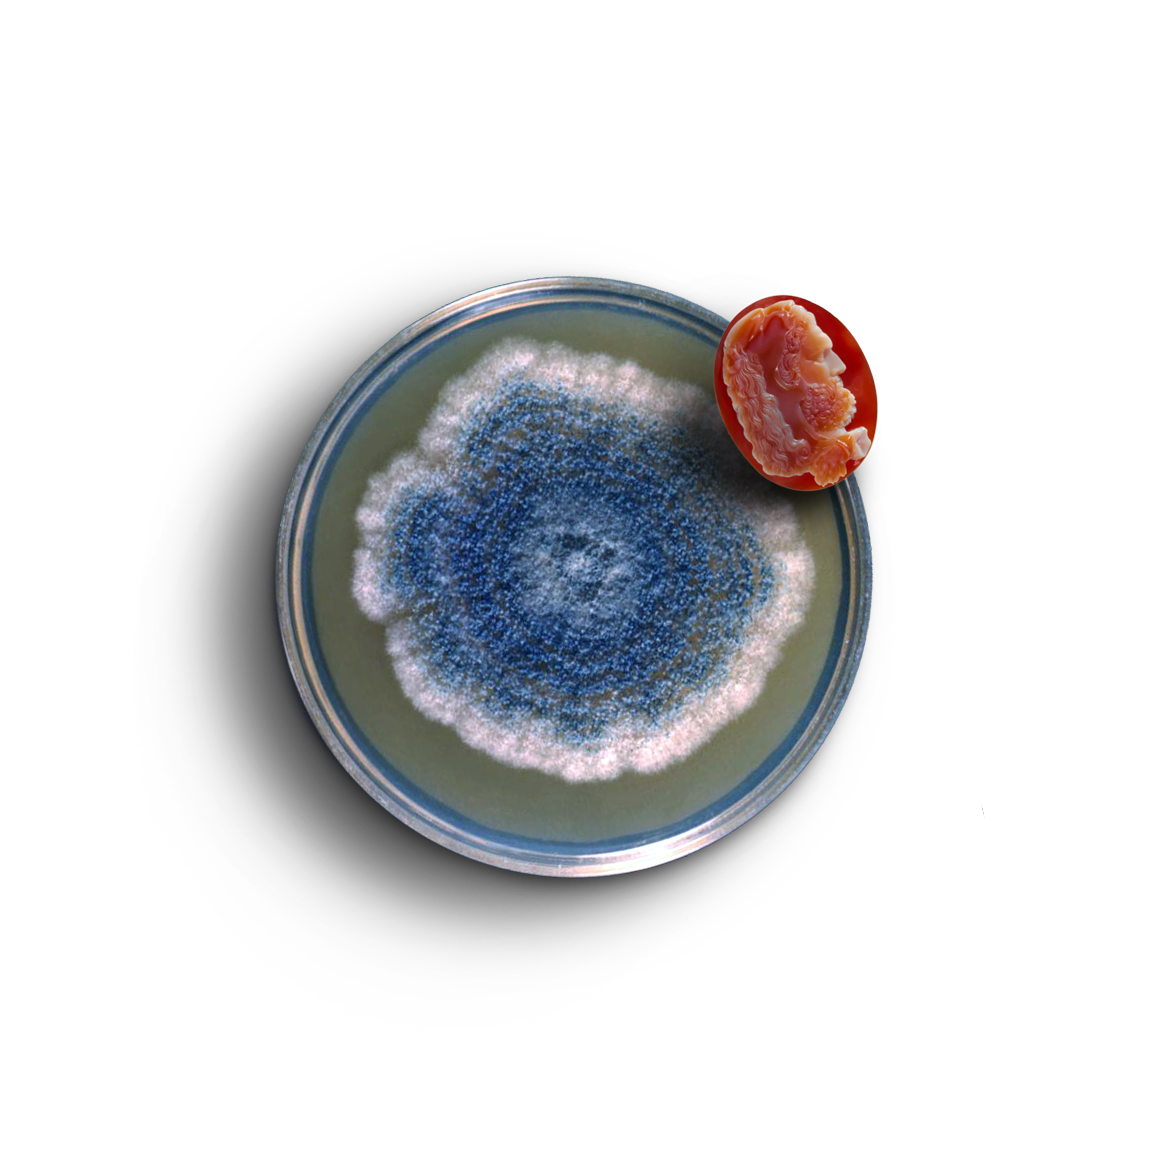

MU PAN "BLOOD:BEGINNING" 2024Issue 02
Issue 02
Issue 02
Issue 02
Issue 02
Issue 02
Issue 02
Issue 02
On the porousness of the self, ecological grief and entanglements, the enormity of interconnection, and how strange and sublime and solitary it is to be a living thing among other living things.
Fifty-two contributors. 176 pages. Available worldwide.
Shipping begins in mid-May. Readers in the US / Canada / UK can order here. Readers in other countries can purchase via Newsstand.


Elastic is a print magazine of psychedelic
art and literature.
We publish visual art and writing that bend time and genre and perspective, blur waking and dreaming life, find sublimity and absurdity in the everyday, magnify the senses, multiply and distort the possibilities of narrative, and interrogate power by breaking form.
The first psychedelic era was a time of radical artistic innovation, and yet, in the popular imagination, "psychedelia" refers to little more than Day-Glo mandalas and contorted mushrooms—a narrow corridor. Elastic is interested in taking the walls down. Or, rather, Elastic is interested in demonstrating that the walls were never really there. These pages conjure a truly expansive vision of psychedelic culture, bringing together a vast body of contemporary psychedelic work and paying tribute to an overlooked archive.
Our first volume, the Dying Issue, is a finalist for the National Magazine Award for Fiction and a Society of Publication Designers award (Design, Independent Publishing, Entire Issue category). Elastic is also a finalist for the 2026 CLMP Firecracker Award in Magazines / Best Debut.
Featuring: Kwaku Osei Owusu Achim, 'Pemi Aguda, Roland Ayers, Gabrielle Bates, Joanna Blémont, Alic Brock, CAConrad, Eric Timothy Carlson, Gina Chung, Mimosa Echard, Enigmatriz, Fernando A. Flores, Devra Fox, Gabriel Gabriel Garble, Sasha Gordon, Alexis Pauline Gumbs, Daisy Hildyard, Key Hiraga, Vivian Hu, Allegra Hyde, David Jien, Jess Johnson, Bhanu Kapil, Chantal Khoury, Haerri Kim, Akil Kumarasamy, Annie Lapin, Dorothea Lasky, Jennifer Latour, Lulu Lin, Kelly Link, Patricia Lockwood, Jesse Mockrin, Lara Mimosa Montes, Moonassi, Mooovooom, Mark Mulroney, Sawako Nakayasu, Josèfa Ntjam, Mu Pan, Kimberly King Parsons, Female Pentimento, Marigold Santos, Daylen Seu, Avigayl Sharp, Brandon Shimoda, Beppe Stasi, Barbara Takenaga, Morgan Thomas, Elissa Washuta, Colin Winnette, Qualeasha Wood, Sara Deniz Akant, Hala Alyan, Aimee Bender, Somnath Bhatt, Venita Blackburn, Melissa Broder, Rita Bullwinkel, K-Ming Chang, Judy Chicago, Anne de Marcken, Steven Dunn, Steven Duong, Edie Fake, Firpal, Sasha Fletcher, Lola Gil, Johanna Hedva, Henry Hoke, Samantha Hunt, Maren Jeleff, Barbara Jones-Hogu, Sawako Kabuki, Miki Kim, Rae Klein, Rebecca Lee, Darian Longmire, Isle McElroy, Wardell Milan, Danylo Movchan, Benoît Paillé, Matthew Palladino, Helen Phillips, Klaus Pichler, Gautam Roy, Eddie Ruscha, Daniel Saldaña París transl. by Christina MacSweeney, Gerardo Sámano Córdova, Margie Sarsfield, sam sax, Devan Shimoyama, Dadu Shin, Jia Sung, Shruti Swamy, Keiichi Tanaami, Armando Veve, Nadia Waheed, Sam Weber, Daisuke Yokota
editor-in-chief
and Publisher
Hillary Brenhouse
contributing editors
Laura van den Berg
Alex Marzano-Lesnevich
Amanda Gunn
Jia Sung
Creative Director
Chloe Scheffe
Meara Sharma
Senior Editor
1


2

1. Mold Culture
2. Harlequin Beetle

S
S
S
S
Stockists
-
Ex-Voto
6534 St Laurent BlvdLibrairie Drawn & Quarterly
176 Rue Bernard OFoil Gallery
6560 Waverly St
-
Issues Magazine Shop
1489 Dundas St W
-
East Bay Booksellers
6022 College Ave, OaklandBathers Library
2310 Telegraph Ave, Oakland
-
Skylight Books
1818 N Vermont Ave
-
McNally Jackson
134 Prince StreetCasa Magazines
22 8th Avenue
-
Rough Draft Bar & Books
82 John Street
-
The City Reader
3050 SE Division St
-
american grammar
2046 N Front St
-
Atomic Books
3620 Falls Road
-
Alienated Majesty Books
613 W 29th St
-
The Sentinel
209 W El Paso Street
-
magCulture
270 St John StreetColours May Vary
The Corn Exchange, Call Ln, LeedsMagalleria
5 Upper Borough Walls, Bath
-
Soft Cover
Stumpergasse 53-55, Vienna, AustriaCahier Central
26 Rue du Château d'Eau, 75010 Paris, France



C
o
n
t
info@elasticmag.coma
Questions? Answers?
info@elasticmag.com
Submissions
submissions@elasticmag.com
c
t
JOSÈFA NTJAM "OCTOMEUTES" 2023
C
o
t
n
t
info@elasticmag.comSubmissions
hello@elasticmag.com
a

c
Partnerships
partnerships@elasticmag.com

C
o
t
n
t
info@elasticmag.comSubmissions
hello@elasticmag.com
a

c
Partnerships
partnerships@elasticmag.com

